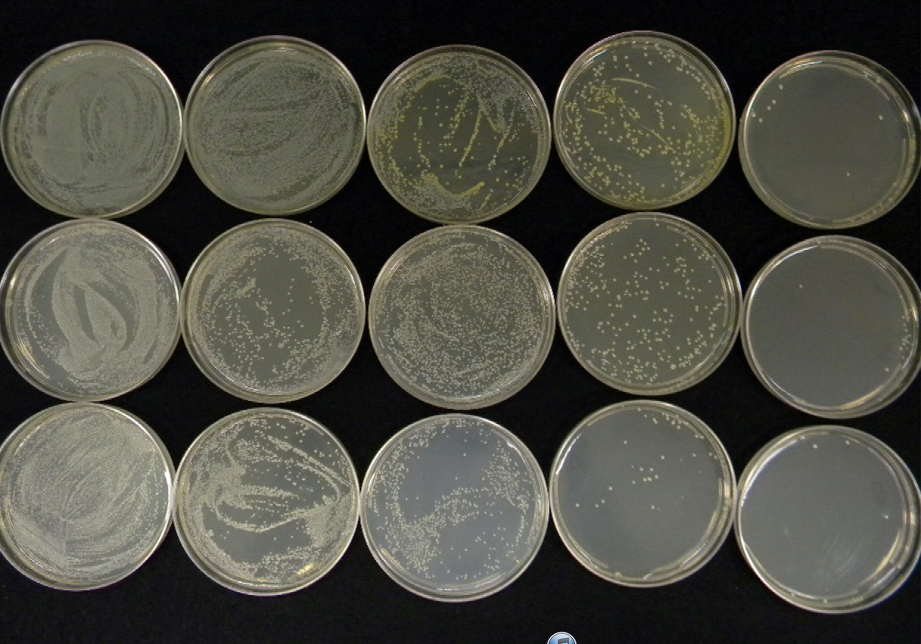
R-C.png

為什麼紫外線照射細胞核會使細胞失去活性?
人們知道,紫外線直接照射皮膚,具有調整和改善神經、內分泌、消化、循環、呼吸、血液、免疫係統以及促進維生素D生成的功能。但是,近年來人們逐漸認識到,過量的紫外線引起光化學反應,可使人體機能發生一係列變化,尤其是對人體的皮膚、眼睛以及免疫係統等造成危害。近年來,在美國、加拿大、澳ao大da利li亞ya等deng國guo及ji我wo國guo一yi些xie城cheng市shi,已yi開kai始shi發fa布bu紫zi外wai線xian指zhi數shu預yu報bao,以yi提ti醒xing公gong眾zhong采cai取qu相xiang應ying的de防fang護hu措cuo施shi。日ri前qian,衛wei生sheng組zu織zhi的de專zhuan家jia們men呼hu籲xu從cong事shi戶hu外wai活huo動dong的de人ren們men要yao避bi免mian長chang時shi間jian在zai日ri光guang下xia曝pu曬shai,到dao海hai濱bin和he山shan區qu度du假jia的de尤you其qi要yao注zhu意yi保bao護hu皮pi膚fu。

紫(zi)外(wai)線(xian)對(dui)人(ren)體(ti)的(de)皮(pi)膚(fu)和(he)眼(yan)睛(jing)的(de)影(ying)響(xiang)為(wei)明(ming)顯(xian)。皮(pi)膚(fu)對(dui)紫(zi)外(wai)線(xian)的(de)吸(xi)收(shou)與(yu)其(qi)波(bo)長(chang)有(you)關(guan)。波(bo)長(chang)越(yue)短(duan),透(tou)入(ru)皮(pi)膚(fu)的(de)深(shen)度(du)越(yue)小(xiao),照(zhao)射(she)後(hou)黑(hei)色(se)素(su)沉(chen)著(zhe)較(jiao)弱(ruo);波長越長,透入皮膚的深度越大,照射後黑色素沉著較強。由於受光化學反應的作用,能級較高的光子流能引起細胞內的 ... 白和一些酶的變性。因此,被紫外線照射後,需經過6—8小時的潛伏期後才發生細胞的改變並出現症狀,包括皮膚幹痛、表皮皺縮,甚至起泡脫落。因紫外線對組織的穿透力很弱,皮膚下的深層組織較少受傷。但嚴重的紫外線,可引起人體疲乏、低熱、嗜睡等全身反應。有些人的皮膚由於對紫外線過敏,光照後發生日光性皮炎(又稱曬傷),暴露區皮膚瘙癢、刺痛、皮膚脫屑,還可能潰破結痂。實際觀測表明,在海拔3500米的高原地區(紫外線通常為平原地區的3—4倍), ... 皮膚在中午前後紫外線照射下,持續20—40分鍾,皮膚有灼痛感且脫皮;持續40—80分鍾,皮膚會起丘疹狀水泡並導致各種病變。
長期、多次的曝曬,可造成皮膚和粘膜的日光性角化症(光照性角化症),表現在暴露部位(如額部、頰部、鼻尖、唇、眼瞼、結膜)出現單個和多個平頂形角化層增厚。據醫學分析,這是一種癌前期變化。研究表明,紫外線能引起細胞核內脫氧核糖核酸(DNA)的損傷,由於機體內在的缺陷,使細胞不能對損傷的DNA進行修複,從而發生對變異DNA的複製,若機體的免疫係統不能及時排斥,清除這種變異的細胞,即機體免疫監視功能有缺陷,這種變異DNA的細胞將發生增殖,終導致腫瘤的形成。因此,紫外線是皮膚的一個重要致癌因素。
上海峰誌儀器有限公司提供多種實驗室用紫外輻照輻照設備,有各種波段(UV-A、UV-B、UV-C)紫外線輻照箱、紫外線交聯儀、台式紫外線燈、便攜式紫外燈,具體請電話或.谘詢網頁底部.




添加微信谘詢!